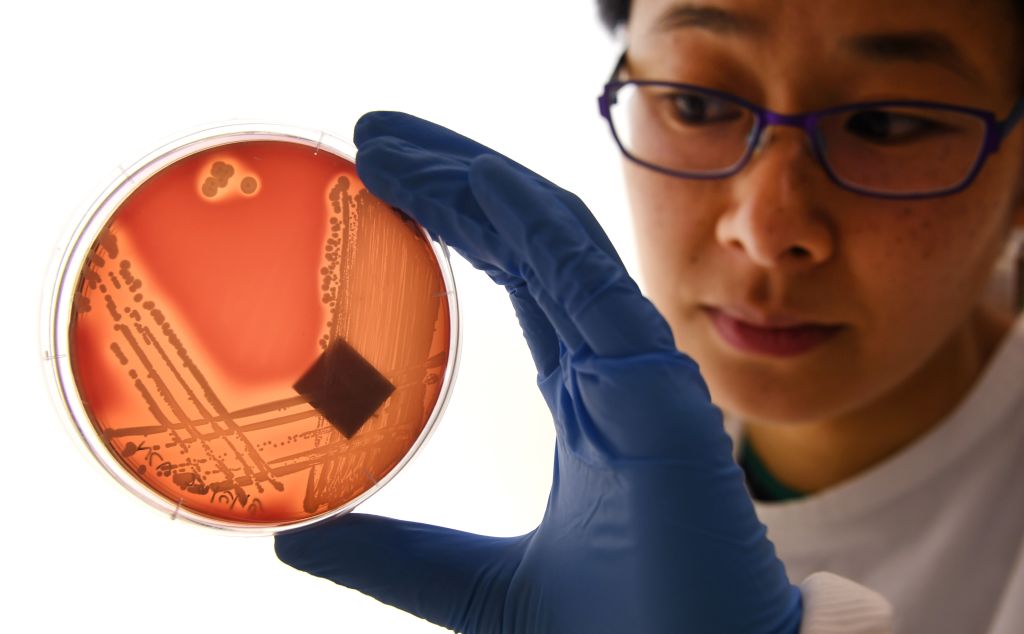
AUSTRALIA-HEALTH-HOSPITAL-DISEASE-SUPERBUG

Superbugs

HealthDeadly drug-resistant fungus has spread across the U.S. Here’s what you need to know about Candida auris
By Chloe TaylorMarch 21, 2023
By Lucas LaursenNovember 7, 2018

By Sy MukherjeeAugust 3, 2018

By David MeyerApril 4, 2018

HealthThe U.K. Just Confirmed Its 1st Case of ‘Super Gonorrhea.’ And It’s Freaking Out Health Experts
By Sy MukherjeeMarch 29, 2018

By Sy MukherjeeJuly 8, 2017

By Sy MukherjeeFebruary 27, 2017
Most Popular








